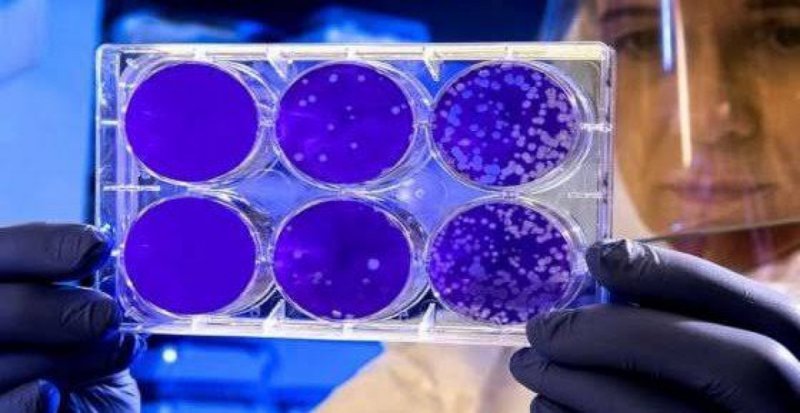

¿La luz ultravioleta acaba con el coronavirus? Esto dice un estudio de la universidad de Boston
Desde que empezó la crisis sanitaria del Coronavirus y el Estado de Alarma por toda Europa, uno de los artículos que experimentaron un auge en ventas fueron los dispositivos esterilizadores de luz ultravioleta. Estos gadgets consisten en una caja en la que meter el móvil u otros objetos - dispositivos y activar una serie de rayos UV que esterilizarán el terminal. De hecho incluso se usan robots en España que desinfectan hospitales usando rayos UV.
Luz ultravioleta UV-C
Pero, ¿se podría usar la luz UV no solo para desinfectar, sino para matar a la COVID-19? El fabricante de material lumínico Philips Lightning -que se ha cambiado el nombre de empresa al de Signify- decidió poner el grado de efectividad de este tipo de luz a examen, y para ello se asoció con la Universidad de Boston, EEUU, en una investigación conjunta dirigida por el doctor Anthony Griffiths, profesor asociado de Microbiología de la Facultad de Medicina, como recoge la compañía holandesa en un comunicado.
El objetivo: Probar la efectividad de la luz ultravioleta UV-C en la desactivación del virus SARS-COV-2 que causa la COVID-19, algo que se logra tras sólo unos segundos de exposición. Griffiths y su equipo inocularon distintos materiales con muestras de Coronavirus, y a continuación probaron a eliminarlo con diferentes dosis de radiación ultravioleta UV-C a través de dispositivos desarrollados por Signify, evaluando en el proceso la capacidad de inactivación en diversas condiciones.
Eliminado en un 99% en segundos
¿El resultado? Un virus desactivado en segundos: Como leemos en Europa Press, el equipo aplicó una dosis de 5mJ/cm2, lo que resultó en una inactivación del virus SARS-COV-2 del 99 por ciento en 6 segundos. Sobre la base de los datos, se determinó que una dosis de 22mJ/cm2 provocará una reducción del 99,9999 por ciento en 25 segundos.??
Por tanto, el estudio ha "confirmado la efectividad de las lámparas UV-C como una medida preventiva para las empresas e instituciones que quieren proporcionar espacios libres de virus", según Eric Rondolat, CEO de Signify, que ya ha anunciado que aumentará su capacidad de producción en los próximos meses y que pondrá su tecnología UV-C al servicio del resto de empresas de iluminación.